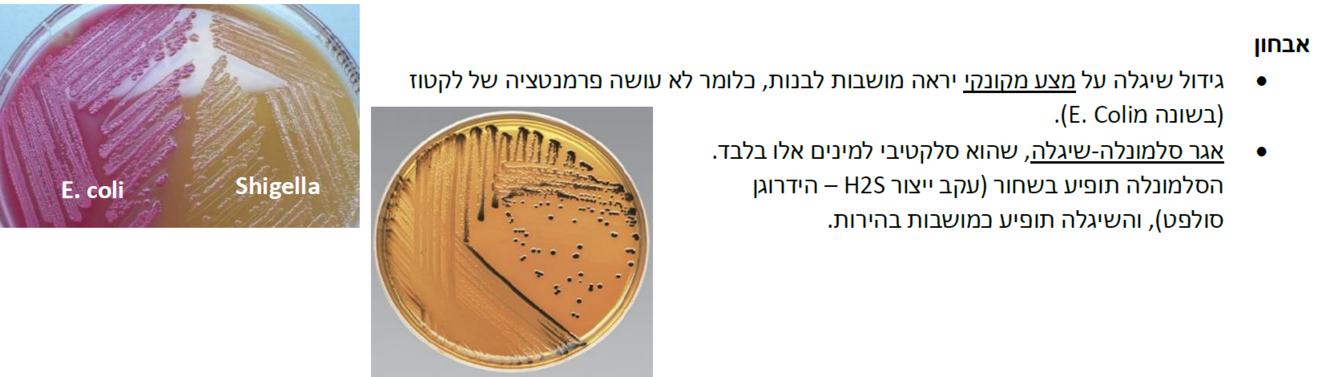

מיהם חיידקי המעיים הגרם שליליים עליהם למדנו, מאיזה
Phylum
הם? איזה ענפים יש בפילום הזה?
מיהם החיידקים הגרם חיוביים עליהם למדנו?

איזה
genus
כולל בתוכו האנטרובקטריה?
מה זה מחלה שנגרמת מהחיידקים הללו באופן אנדוגני? מה זה אקסוגני?

תארי את האנטרובקטריה:
גרם חיובי או שלילי?
גדלים בתנאים אירוביים או אנארוביים?
האם יש להם את האנזים
oxidase?
ממה מורכב ה
LPS
שיש להם בדופן?
האם יש להם קפסולה?
איזה סוג של
secretion system
יש להם?

איזה חיידק מעניין מוגדר תחת
Escherichia coli
(???)
לאיזה מחלות הוא גורם? האם הזיהומים הם אנדוגנים או אקסוגנים?
תחת
Escherichia coli
יש 6 מינים, בהם המעניין הוא
E.coli
הזיהומים שהוא יוצר הם לרוב אנדוגנים כלומר הגיעו מהמעיים לאיזור אחר בגוף. הזיהומים:
זיהום בדרכי השתן
זיהום בדם =
septicemia
Neonatal Meningitis
יכול לגרום לזיהום במערכת העיכול (לרוב אקסוגני)
אצל מי יותר שכיח זיהום בדרכי השתן, אצל נשים או גברים? מתי יופיע אצל גברים? מה זה אומר שחיידק הוא
Uropathogenic?
מה יש לו?

מה זה ספסיס? מאיפה מגיע
E coli
לדם?

Neonatal meningitis
איך הוא עובר מהאמא לילוד?
מה גורם הסיכון של תינוקות לחלות בזה?

מהם הזנים השונים של חיידקי ה
E coli
שגורמים לזיהומים במעיים?
היא מרצה ממש גרועה יש לציין
ETEC אנטרוטוקסוגני
EPEC אנטרופתוגני
EAEC enteroaggregative
STEC - shiga toxin
EHEC אנטרו-המורגי
EIEC - Enteroinvasive
פירוט עליהם בכרטיסיות המשך
איזה חיידק הוא הסיבה העיקרית לשלשולים במדינות מתפתחות? האם השלשושים מכילים דם? איזה טוקסינים החיידקים מפרישים?

למה גורם החיידק
EPEC?
האם יש לו טוקסינים?מהם גורמי האלימות שלו? למה הם גורמים?

למה גורם החיידק
EAEC?
איך החיידקים משפיעים על הגוף, למה הם גורמים?
מה יתווסף לשלשולים?

STEC and EHEC
באיזה מדינות החיידקים הללו מהווים בעיה?
מה הם המאפיינים של המחלה
Hemolytic-uremic syndrome
מהם שני הטוקסינים שהחיידקים מפרישים? מה כל טוקסין עושה?
מה זה
Hemorrhagic Colitis?

החיידק
EIEC
לזיהום של איזה חיידק הוא דומה? במה הוא דומה לו?
מה החיידק עושה?

איך מאבחנים במעבדה את החיידק אי קולי?
הסיכום סופר מבולגן לא מצליח לשאול שאלות נוספות

איזה זנים של החיידק
shigella
יש?
איזה מהם מחולל את מחלת הדיזנטריה? איזה נזק הוא עושה לאפיתל?

באיזה בעלי חיים שיגלה גורם למחלה? איך מתבצעת ההדבקה? כמה חיידקים דורשת ההדבקה? מה זה
shigellosis?
מה התסמינים? מה החיידק עושה למעי הגס? איזה סוג של שיגלה הוא הגורם העיקרי למחלה?
לאיזה חיידק שיגלה דומה?

דרך איזה תאים תוקף חיידק השיגלה? דרך איזה תאים הם מתחמקים ממערכת החיסון? באיזה סוג של
secretion
החיידקים משתמשים? למה גורם מה שהם מפרישים?
איזה אנטיביוטיקה נותנים נגד החיידק?

אבחון של חיידק השיגלה:
איך יראה גידול של חיידק השיגלה על מצע מקונקי?
באיזה סוג של אגר נשתמש כדי לזהות אותו?
ההמשך הוא סלמונלה עמוד 93 למטה


